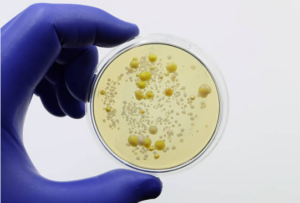

Bad Actors
We mention “bad actors” frequently on our website because there are so many of them in the industrialized food supply. It is our goal to raise awareness about this fact so that we might contribute to improving your health. To better understand what these bad actors are and why they